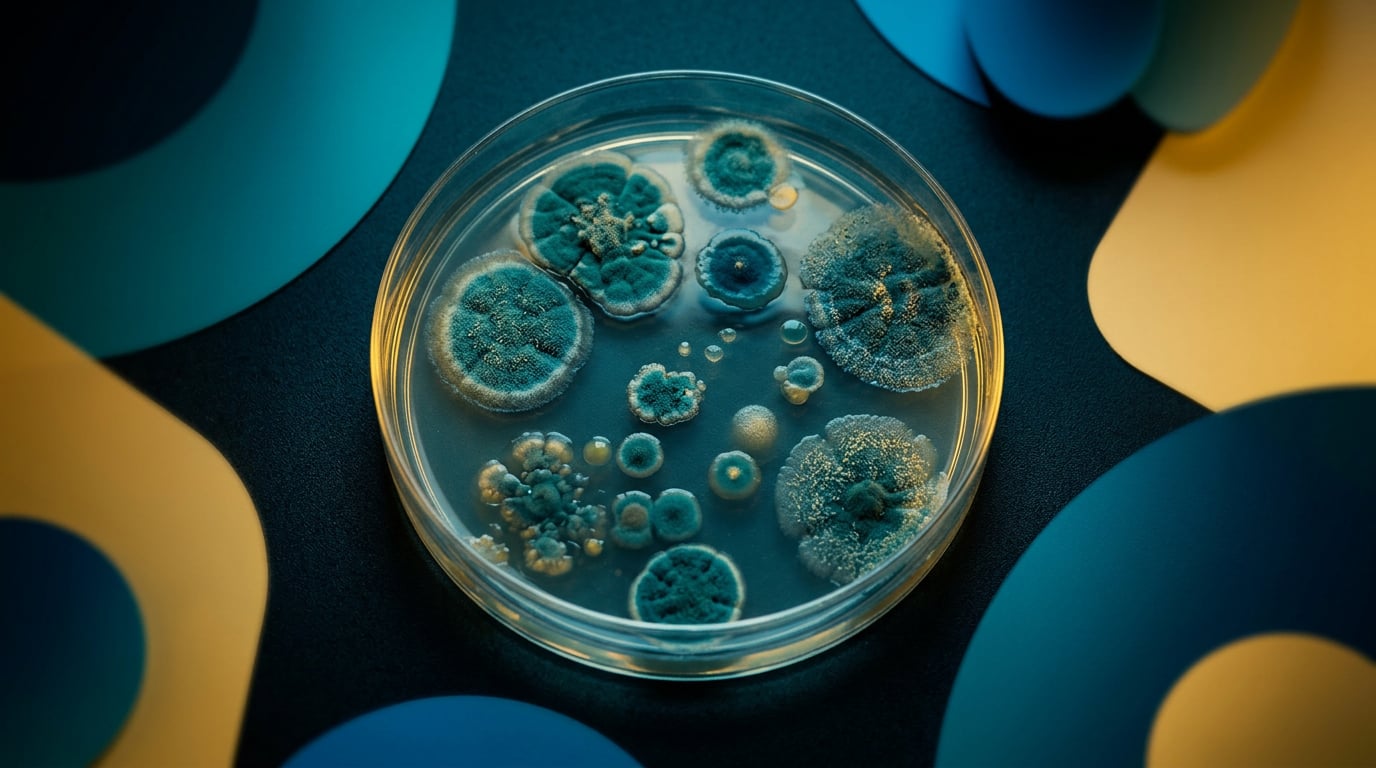
Seres Therapeutics annual profit jumps on asset sale, but faces cash crunch

Seres Therapeutics (NASDAQ:MCRB) delivered a rare profitable year in 2025, though the black ink was the result of a major divestiture rather than a surge in drug sales.
The Cambridge, Massachusetts-based microbiome specialist reported a full-year profit of $5.7 million, or $0.64 per share, reversing a massive $125.8 million loss from the prior year.
The turnaround was fueled by an $80.7 million gain from the sale of its VOWST business—the first FDA-approved oral microbiome therapeutic—to Nestlé Health Science.
Despite the annual profit, the company’s fourth-quarter results highlighted the persistent burn rate of its remaining clinical programs.
For the three months ended Dec. 31, Seres posted a net loss of $15.3 million, or $1.76 per share, on revenue of just $438,000.
Under the leadership of newly appointed interim CEO Richard Kender, Seres is undergoing a radical "reboot."
The company is pausing internal investment in its most advanced candidate, SER-155, while it hunts for a partner to fund Phase 2 trials.
Instead, resources are being diverted toward earlier-stage immunological research, supported by a 30% workforce reduction aimed at preserving capital.